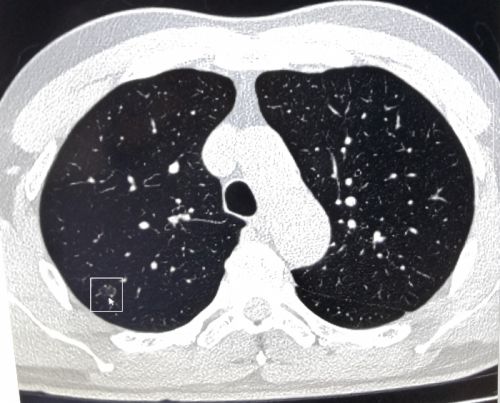

张先生体检时肺部ct筛查影像显示有可疑结节(箭头处)。

复查肺穿刺活检,确诊张先生为早期“微小浸润性肺腺癌”。

体检者到湖南省人民医院岳麓山院区健康管理中心结节筛查门诊就诊。
近日,长沙57岁的张先生到湖南省人民医院岳麓山院区健康管理中心做健康体检时提出,胃肠道有些不适,想做胃肠镜等项目。中心主任李慧根据其咳嗽症状、吸烟史和年龄等因素,建议增加肺部CT项目。张先生觉得没必要,经过李慧主任耐心解释后欣然接受,结果CT显示“右上肺可见大小约8×6mm结节”,建议跟踪复查,每半年一次。
李慧主任看了检查结果后非常重视,要求中心回访医生缩短标准回访跟踪间隔时间。一个月后,工作人员进行电话回访时,建议张先生到健康管理中心肺结节门诊就诊。看门诊时,医生给张先生复查了低剂量高清晰肺部增强CT,显示右上肺结节较上次变大,立即安排肺穿刺活检,确诊为“早期微小浸润性肺腺癌”。幸运的是,由于回访跟踪及时,尚属肺癌早期。住院做了根治手术后,张先生目前状态良好。
湖南省人民医院岳麓山院区健康管理中心对体检发现肺部结节、肝脏结节、甲状腺结节、乳腺结节、前列腺结节等异常者均进行定期回访跟踪,疑似恶性结节的回访跟踪间隔时间更短。回访时,工作人员会耐心叮嘱体检者按时复查,或建议其到中心开设的结节门诊就诊,让体检者在健康管理中心就能把部分临床问题解决,真正做到早发现、早治疗。
“结节门诊的设立,延伸了中心检后服务内容,提高了检后服务质量,为体检者提供更加全面、优质的体检体验和健康服务”,李慧介绍,岳麓山院区健康管理中心从今年11月以来陆续开设结节筛查门诊和生活方式干预门诊,由医院临床科室资深专家坐诊,有“结节”和“三高”等困扰的体检者在这里可以得到动态回访跟踪、提前预约专家号等特色服务,更早发现健康隐患。
湖南省人民医院健康管理中心门诊安排
|
名称 |
周一下午 |
周二下午 |
周三下午 |
周四下午 |
周五下午 |
|
生活方式干预门诊 |
|
|
|
|
罗大光 副主任医师 |
|
肝结节筛查门诊 |
|
唐世刚 主任医师 |
|
向斌 副主任医师 |
|
|
肺结节筛查门诊 |
|
周亚夫 副主任医师 |
|
|
|
|
前列腺筛查门诊 |
|
|
杨科 主任医师 |
|
|
|
胃肠结节筛查门诊 |
彭娅 副主任医师 |
|
|
|
|
就诊地点:湖南省人民医院岳麓山院区健康管理中心(长沙市岳麓区平川路90号)
生活方式干预门诊、肺结节筛查门诊,前列腺筛查门诊、胃肠结节筛查门诊:健康管理中心四楼415室
肝结节筛查门诊:健康管理中心四楼419室
文图:梁辉 吴文娟 曾志节